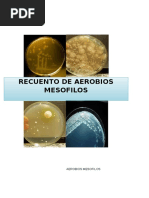

0% encontró este documento útil (0 votos)
935 vistas18 páginasAnalisis Microbiologico de Alimentos
El documento describe los métodos para analizar microorganismos presentes en alimentos. Explica que se analizan los microorganismos para determinar la calidad de un alimento y si es apto para el consumo. Describe los métodos de cultivo, recuento en placa, pruebas bioquímicas e inmunológicas para identificar bacterias, hongos y levaduras presentes.
Cargado por
Luis Alfonso Beltran CottaDerechos de autor
© © All Rights Reserved
Nos tomamos en serio los derechos de los contenidos. Si sospechas que se trata de tu contenido, reclámalo aquí.
Formatos disponibles
Descarga como PPTX, PDF, TXT o lee en línea desde Scribd
0% encontró este documento útil (0 votos)
935 vistas18 páginasAnalisis Microbiologico de Alimentos
El documento describe los métodos para analizar microorganismos presentes en alimentos. Explica que se analizan los microorganismos para determinar la calidad de un alimento y si es apto para el consumo. Describe los métodos de cultivo, recuento en placa, pruebas bioquímicas e inmunológicas para identificar bacterias, hongos y levaduras presentes.
Cargado por
Luis Alfonso Beltran CottaDerechos de autor
© © All Rights Reserved
Nos tomamos en serio los derechos de los contenidos. Si sospechas que se trata de tu contenido, reclámalo aquí.
Formatos disponibles
Descarga como PPTX, PDF, TXT o lee en línea desde Scribd